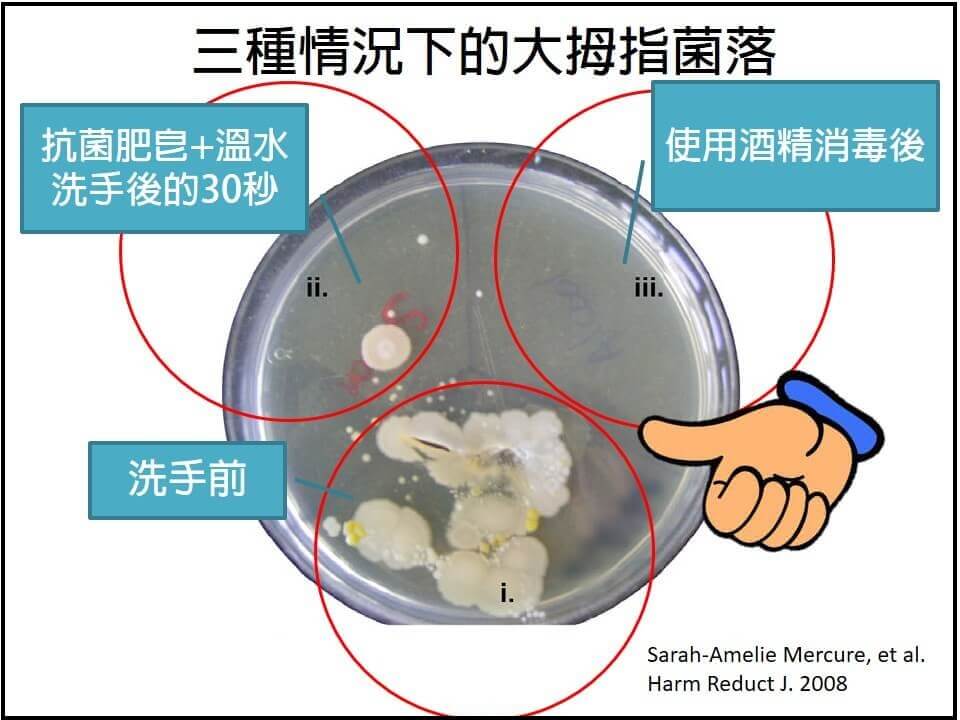
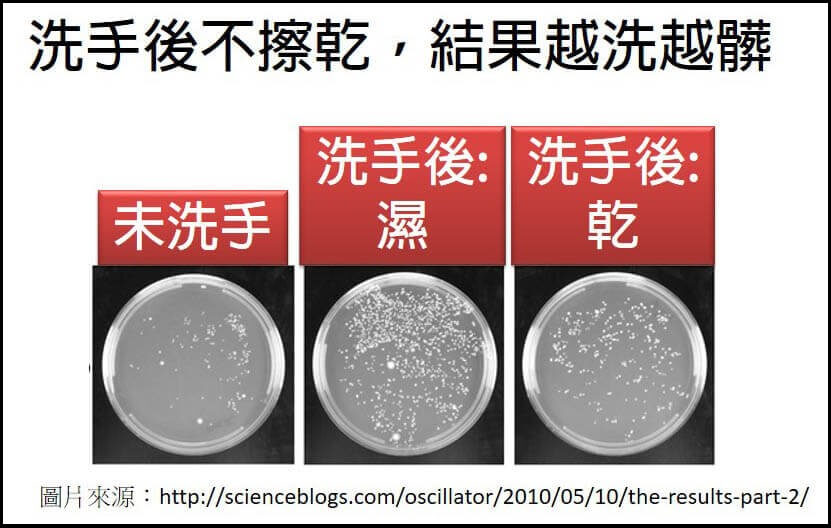

洗手少了擦乾這一步,細菌反而增加8成
洗手洗20秒是有科學根據的,因為實證發現洗15~30秒,才能洗掉手上大多數的病菌。洗手五步驟,最後一個”擦”,指的是擦乾手,別小看這個步驟,國內曾做過實驗,洗手後若未擦乾,手上細菌數竟比洗手前暴增逾8成,這是因為肥皂、洗手乳、水龍頭、衣服、毛巾……上都有病菌,讓雙手保持潮濕的狀態,反而更容易讓病菌附著、滋生,形成越洗越髒的窘境,如下圖,可以明顯看出,洗完手後不立即擦乾(中間),30分鐘後菌落數比洗手前多。
洗手至少20秒,延長孩子洗手的好方法
在洗手5步驟「濕、搓、沖、捧、擦」中,搓與擦是殺菌的關鍵,因「病毒、細菌有吸附力,一定要透過搓、擦的物理摩擦作用,才能把它們有效除掉。」但往往小朋友都只有搓一下下,有搓就好,美國CDC建議可以請孩子唱兩次生日快樂歌,就差不多20秒囉!爸爸媽媽可以試試看。
延伸閱讀:




